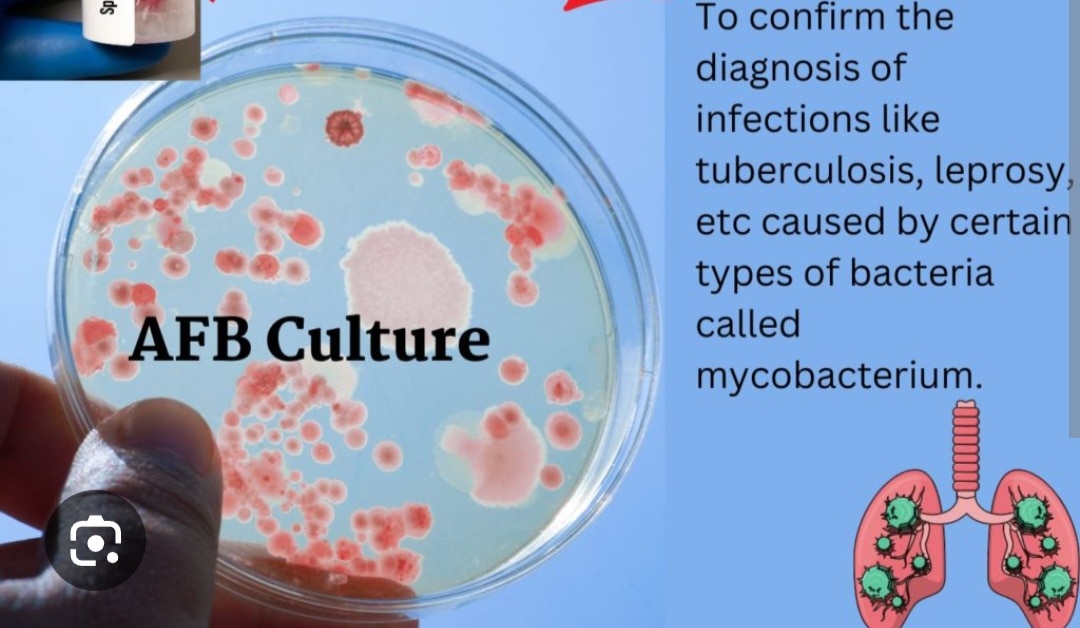
A393➡️AFB Rapid Culture, Pus/Abscess/Aspirates

This is your website preview.
Currently it only shows your basic business info. Start adding relevant business details such as description, images and products or services to gain your customers attention by using Boost 360 android app / iOS App / web portal.